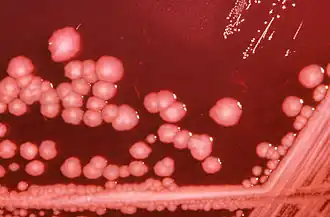
P. mirabilis on an XLD agar plate.

Proteus mirabilis
Proteus mirabilis
| |||||||||||||||
|---|---|---|---|---|---|---|---|---|---|---|---|---|---|---|---|
![]() P. mirabilis on an XLD agar plate. | |||||||||||||||
| Classificação científica | |||||||||||||||
| |||||||||||||||
| Nome binomial | |||||||||||||||
| Proteus mirabilis Hauser 1885 | |||||||||||||||
Proteus mirabilis é uma bactéria gram-negativa, anaeróbia facultativa, em forma de bastonete, com motilidade e capaz de produzir grandes quantidades de urease. P. mirabilis é responsável por 90% de todas as infecções em humanos por bactérias Proteus. Está amplamente distribuída pelo meio ambiente, em matéria orgânica, no solo e na água. É um tipo de enterobactérias e pode fazer parte da flora normal de intestino.[1]
Esta espécie também possui um tipo de motilidade descrita como swarming (enxame), do qual, quando inoculada em um meio mais solidificado, as células se diferenciam tornando-se maiores e superexpressando flagelos. Em uma placa de ágar, o swarming terá anéis concêntricos característicos, em razão das células móveis que partem do centro do inóculo.[7]
Por ser uma gram-negativa, pode ser isolada em ágares seletivos como MacConkey (sendo evidenciada como bactéria lactose-negativa).
Também já foi isolada e caracterizada por Sanches et al., cepas de Proteus mirabilis de carnes de frango, bovina e suína possuindo 100% de similaridade genética entre Proteus mirabilis oriundos de infecções do trato urinário adquiridas em comunidade (ITU-AC), evidenciando o potencial risco zoonótico desta enterobactéria. [8]
Patogênese
Proteus mirabilis dispõe de diversos fatores de virulências que possibilitam desde a colonização do hospedeiro à produção de toxinas, como, exemplo, fímbrias, adesinas, hemolisinas, urease e receptores de sideróforos (responsável pela quelação e sequestro de ferro do hospedeiro). No que tange as fímbrias, as mais estudadas incluem:
- MR/P (Mannose-resistant Proteus-like fimbriae);
- UCA (Uroepithelial cell adhesin, anteriormente NAF, Non-aggregative fimbriae);
- MR/K (Mannose-resistant Klebisella-like fimbriae);
- PMF (Proteus mirabilis fimbriae);
- ATF (Ambient-temperature fimbriae).
Além de permitirem a colonização do trato urinário do hospedeiro, as fímbrias, em particular MR/P, contribuem para o processo de formação do biofilme ao mediar a adesão à superfície e a autoagregação. [5]
Quando invade vias urinárias causa infecção urinária alcalina, por converter ureia em amônio pela ação da enzima urease. O aumento da alcalinidade da urina pode levar à formação de cristais de estruvita, carbonato de cálcio e/ou apatita (pedras nos rins). As bactérias podem permanecer dentro das pedras nos rins que enquanto não forem removidas podem reiniciar a infecção após o tratamento antibiótico. Conforme as pedras aumentam de tamanho podem eventualmente crescer o suficiente para causar obstrução das vias urinárias e insuficiência renal. [2]
Proteus também podem causar infecções de feridas, infecções oculares, no canal auditivo, sepse e pneumonia, principalmente em pacientes hospitalizados e imunodeprimidos. A literatura também já demonstrou casos de meningoencefalite neonatal ocasionada por Proteus mirabilis. [6]
Tratamento

P. mirabilis é geralmente mais suscetível a antibióticos exceto por tetraciclinas, mas 10 a 20% das estirpes de P. mirabilis são resistentes à primeira geração de cefalosporinas e a ampicilina.
Pacientes sem complicações podem ser tratados em ambulatório com uma quinolona oral por 3 dias ou trimetoprim/sulfametoxazol (TMP/SMZ) por 3 dias. Para os pacientes hospitalizados, a terapia é parenteral e consiste em ceftriaxona, quinolona, gentamicina (mais ampicilina) ou aztreonam até passar a febre. Em seguida, uma quinolona oral, cefalosporina ou TMP / SMZ durante 14 dias para completar o tratamento e evitar resistências.[3]
Pielonefrite aguda não complicada em mulheres pode ser tratado com quinolonas ou cefalosporinas orais por 7-14 dias, ceftriaxona em dose única ou gentamicina seguido de TMP/SMZ por 14 dias.[3]
Sequenciamento genético
A primeira seqüência do genoma completa para P. mirabilis, que inclui pelo menos 3693 genes e 4,063 megabases de DNA, foi apresentada na 106a reunião da Sociedade Americana de Microbiologia.[4]